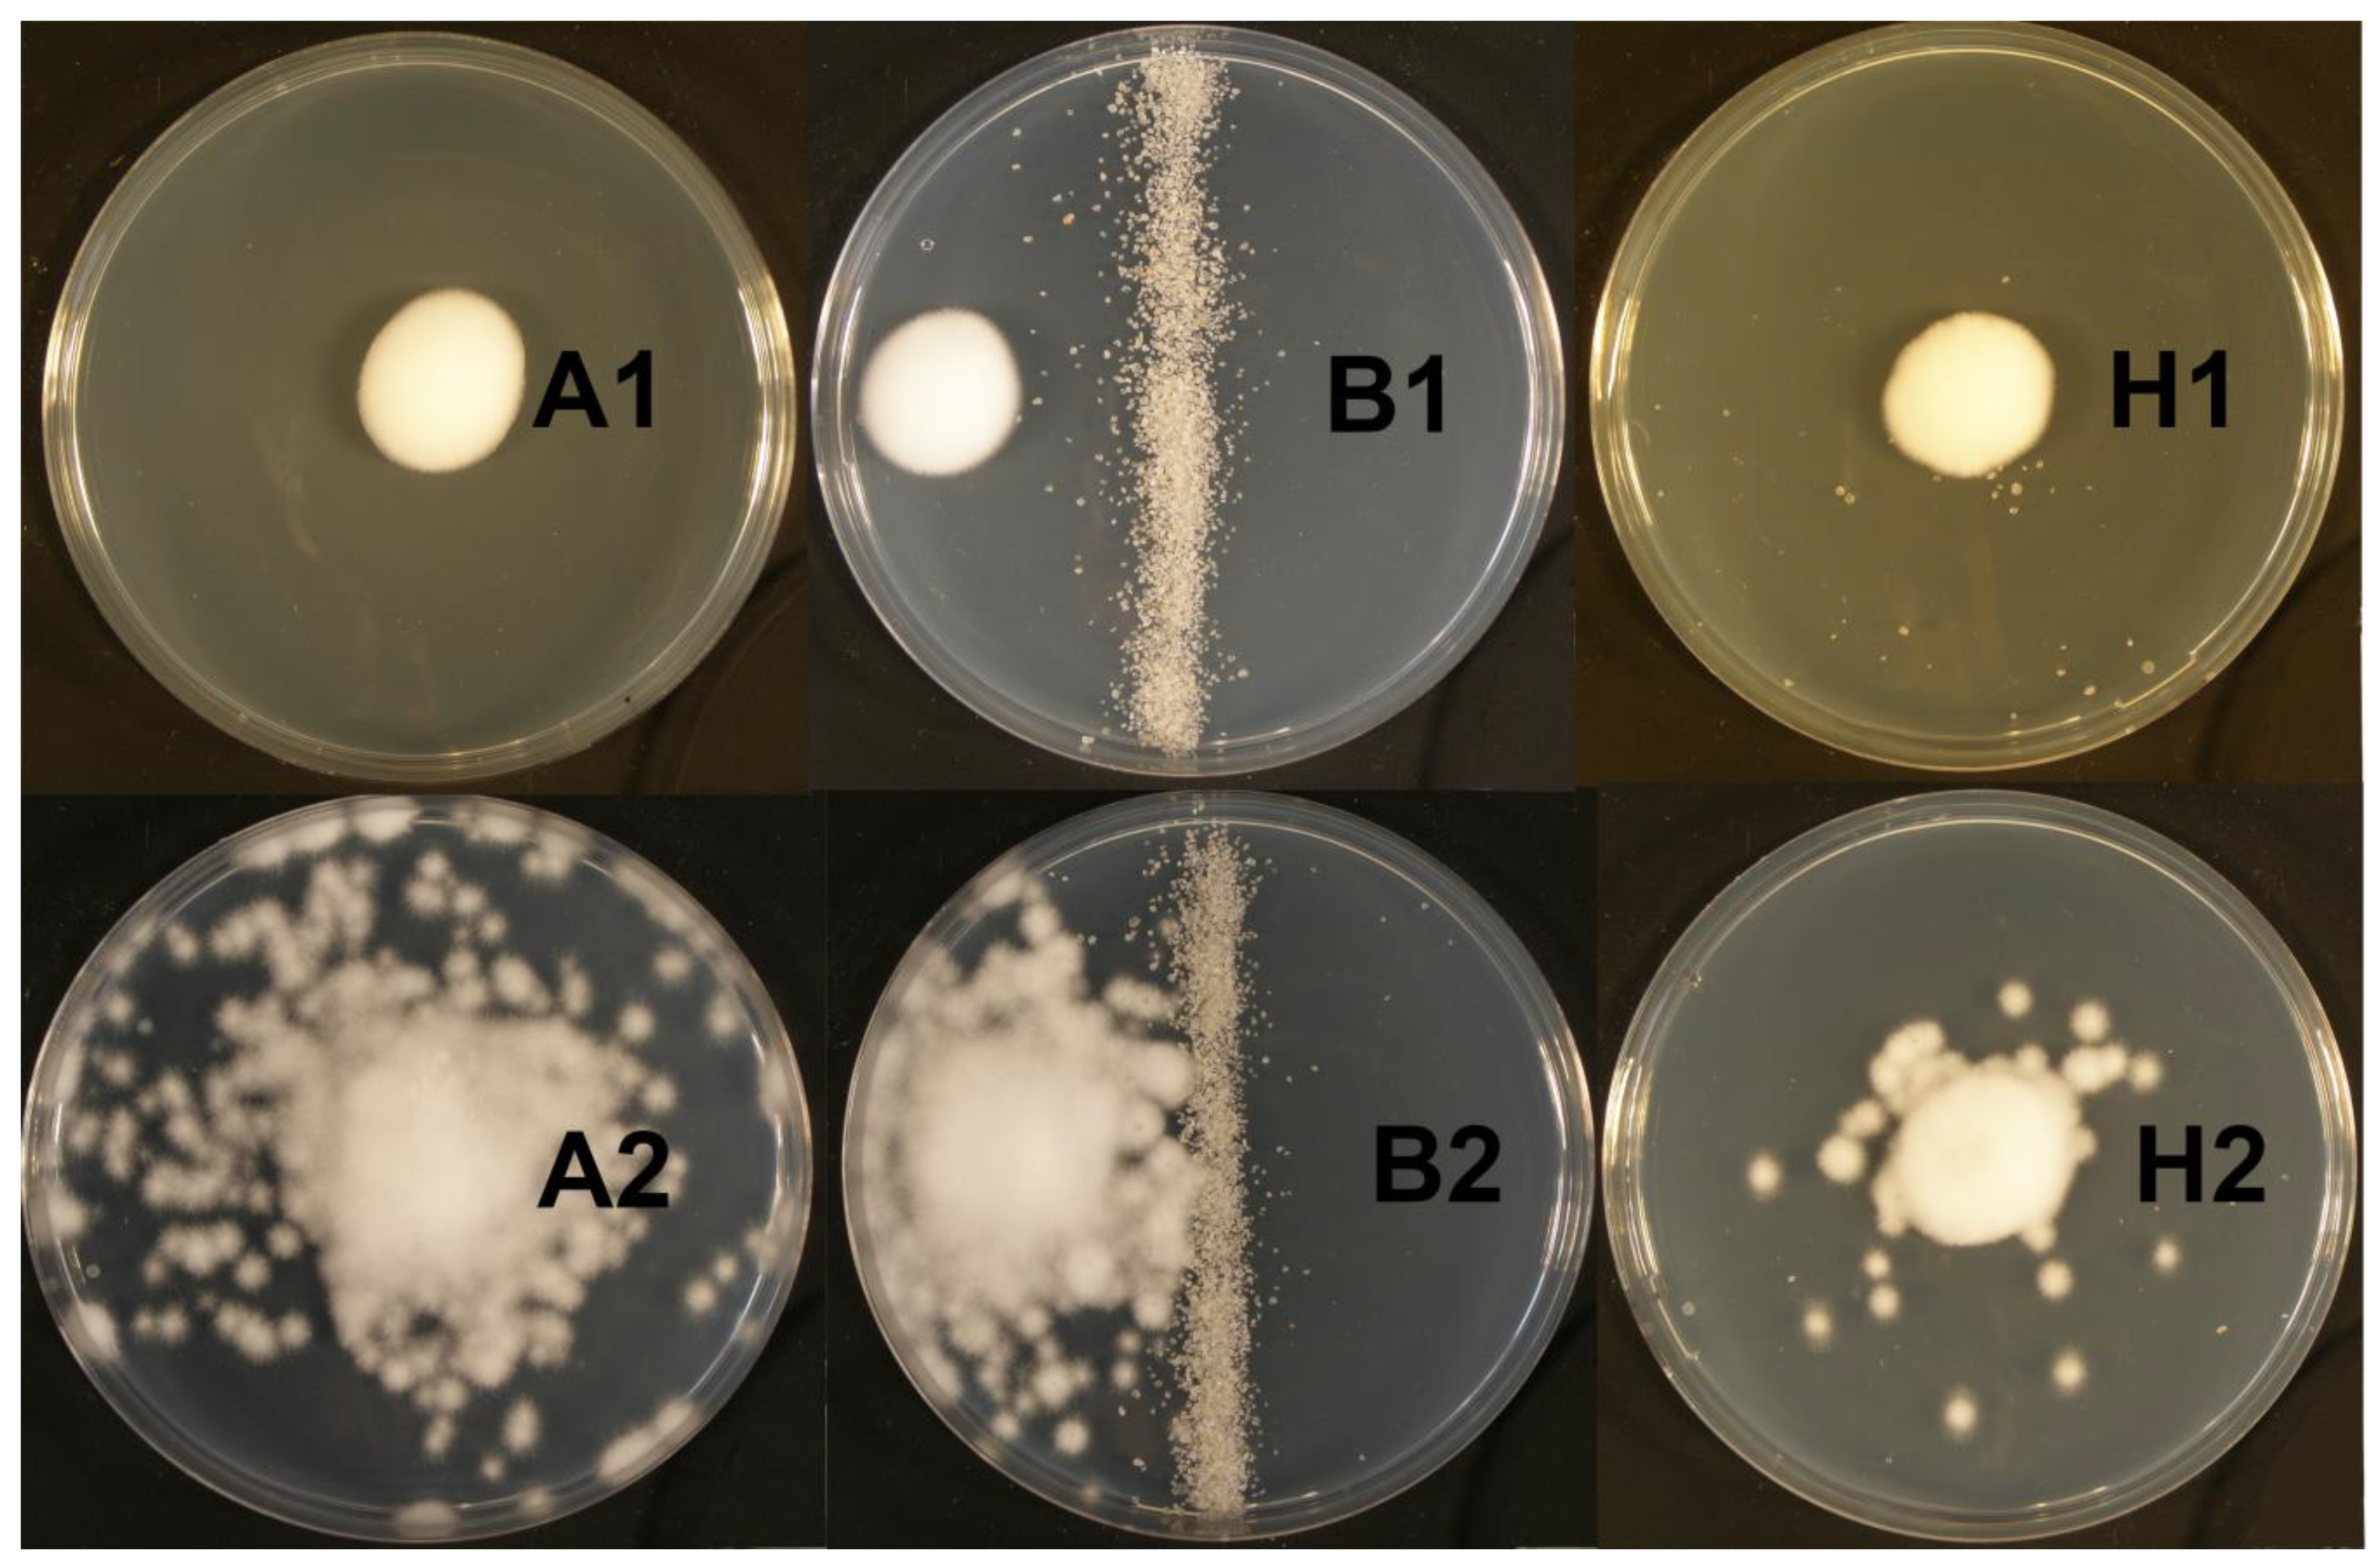

Dissemination of Isaria fumosorosea Spores by Steinernema feltiae and Heterorhabditis bacteriophora
Abstract
1. Introduction
2. Materials and Methods
2.1. Experimental Organisms
2.2. Agar Plate Experiments
2.3. Glass Tube Experiments
2.4. Statistical Analyses
3. Results
3.1. Agar Plate Experiments
3.2. Glass Tube Experiment
4. Discussion
5. Conclusions
Author Contributions
Funding
Acknowledgments
Conflicts of Interest
References
- Boemare, N.; Akhurst, R.; Mourant, R. DNA relatedness between Xenorhabdus spp. (Enterobacteriaceae), symbiotic bacteria of entomopathogenic nematodes, and a proposal to transfer Xenorhabdus luminescens to a new genus, Photorhabdus gen-nov. Int. J. Syst. Bacteriol. 1993, 43, 249–255. [Google Scholar] [CrossRef]
- Poinar, G.O. Nematodes for Biological Control of Insects; CRC Press Inc.: Boca Raton, FL, USA, 1979. [Google Scholar] [CrossRef]
- Gaugler, R.; Lebeck, L.; Nakagake, B.; Bousch, G.M. Orientation of the entomogenous nematode Neoaplectana carpocapsae to carbon dioxide. Environ. Entomol. 1980, 9, 649–652. [Google Scholar] [CrossRef]
- Lewis, E.E.; Gaugler, R.; Harrison, R. Entomopathogenic nematode host finding: Response to host contact cues by cruise and ambush foragers. Parasitology 1992, 105, 309–315. [Google Scholar] [CrossRef]
- Lewis, E.E.; Gaugler, R.; Harrison, R. Response of cruiser and ambusher entomopathogenic nematodes (Steinernematidae) to host volatile cues. Can. J. Zool. 1993, 71, 765–769. [Google Scholar] [CrossRef]
- Grewal, P.S.; Gauler, R.; Selvan, S. Host recognition by entomopathogenic nematodes—Behavioural response to contact with host feces. J. Chem. Ecol. 1993, 19, 1219–1231. [Google Scholar] [CrossRef]
- O’Halloran, D.M.; Burnell, A.M. An investigation of chemotaxis in the insect parasitic nematode Heterorhabditis bacteriophora. Parasitology 2003, 127, 375–385. [Google Scholar] [CrossRef]
- Půža, V.; Mráček, Z.; Nermuť, J. Novelties in Pest Control by Entomopathogenic and Mollusc-Parasitic Nematode. In Integrated Pest Management (IPM): Environmentally Sound Pest Management; Gill, D.H., Ed.; InTech: Rijeka, Croatia, 2016; pp. 71–102. [Google Scholar] [CrossRef]
- Butt, T.M.; Goettel, M.S. Bioassays of Entomogenous Fungi. In Bioassays of Entomopathogenic Microbes and Nematodes; Navon, A., Ascher, K.R.S., Eds.; CAB International: Wallingford, UK, 2000; pp. 141–195. [Google Scholar] [CrossRef]
- Meyling, N.V.; Eilenberg, J. Ecology of the entomopathogenic fungi Beauveria bassiana and Metarhizium anisopliae in temperate agroecosystems: Potential for conservation biological control. Biol. Control 2007, 43, 145–155. [Google Scholar] [CrossRef]
- Hajek, A.E.; St. Leger, R.J. Interactions between fungal pathogens and insect host. Annu. Rev. Entomol. 1994, 39, 293–322. [Google Scholar] [CrossRef]
- Inglis, G.D.; Goettel, M.S.; Butt, T.M.; Strasser, H. Use of hyphomycetous fungi for managing insect pests. In Fungi as Biocontrol Agents: Progress, Problems and Potential; Butt, T.M., Jackson, C.W., Magan, N., Eds.; CABI International/AAFC: Wallingford, UK, 2001; pp. 23–69. [Google Scholar] [CrossRef]
- Augustyniuk-Kram, A.; Kram, K.J. Entomopathogenic Fungi as an Important Natural Regulator of Insect Outbreaks in Forests (Review). In Forest Ecosystems-More than Just Trees; Blanco, J.A., Lo, Y.H., Eds.; InTech: Rijeka, Croatia, 2012; pp. 265–294. [Google Scholar] [CrossRef]
- Shah, P.A.; Pell, J.K. Entomopathogenic fungi as biological control agents. Appl. Micobiol. Biotechnol. 2003, 61, 413–423. [Google Scholar] [CrossRef] [PubMed]
- Butt, T.M.; Coates, C.J.; Dubovskiy, I.M.; Ratcliffe, N.A. Entomopathogenic Fungi: New Insights into Host-Pathogen Interactions. In Genetics and Molecular Biology of Entomopathogenic Fungi; Lovett, B., St. Leger, R.J., Eds.; Academic Press: Cambridge, MA, USA, 2016; pp. 307–364. [Google Scholar] [CrossRef]
- Gullan, P.J.; Cranston, P.S. The Insect: An Outline of Entomology; Blackwell Science: Hoboken, NJ, USA, 2000; pp. 385–395. ISBN 978-1-118. [Google Scholar]
- Roy, H.E.; Pell, J.K. Interactions between Entomopathogenic Fungi and Other Natural Enemies: Implications for Biological Control. Biocontrol. Sci. Technol. 2000, 10, 737–752. [Google Scholar] [CrossRef]
- Meyling, N.V.; Eilenberg, J. Isolation and characterisation of Beauveria bassiana isolates from phylloplanes of hedgerow vegetation. Mycol. Res. 2006, 11, 188–195. [Google Scholar] [CrossRef] [PubMed]
- Meadow, R.; Vandenberg, J.D.; Shelton, A.M. Exchange of Inoculum of Beauveria bassiana (Bals.) Vuill. (Hyphomycetes) Between Adult Flies of the Cabbage Maggot Delia radicum L. (Diptera: Anthomyiidae). Biocontrol Sci. Technol. 2000, 10, 479–485. [Google Scholar] [CrossRef]
- Vänninen, I.; Tyni-Juslin, J.; Hokkanen, H. Persistence of augmented Metarhizium anisopliae and Beauveria bassiana in Finnish agricultural soils. BioControl 2000, 45, 201–222. [Google Scholar] [CrossRef]
- Enkerli, J.; Widmer, F.; Keller, S. Long-term field persistence of Beauveria brongniartii strains applied as biocontrol agents against European cockchafer larvae in Switzerland. Biol. Control 2004, 29, 115–123. [Google Scholar] [CrossRef]
- Zemek, R.; Konopická, J.; Bohatá, A. Inoculation of sphagnum-based soil substrate with entomopathogenic fungus Isaria fumosorosea (Hypocreales: Cordycipitaceae). AIP Conf. Proc. 2018, 1954, 030009-1–030009-5. [Google Scholar] [CrossRef]
- Osborne, L.S.; Landa, Z. Biological Control of Whiteflies with Entomopathogenic Fungi. Fla. Entomol. 1992, 75, 456–471. [Google Scholar] [CrossRef]
- De Faria, M.R.; Wraight, S.P. Mycoinsecticides and Mycoacaricides: A comprehensive list with worldwide coverage and international classification of formulation types. Biol. Control 2007, 43, 237–256. [Google Scholar] [CrossRef]
- Jackson, M.A.; Dunlap, C.A.; Jaronski, S.T. Ecological considerations in producing and formulating fungal entomopathogens for use in insect biocontrol. BioControl 2010, 55, 129–145. [Google Scholar] [CrossRef]
- Zimmermann, G. The entomopathogenic fungi Isaria farinosa (formerly Paecilomyces farinosus) and the Isaria fumosorosea species complex (formerly Paecilomyces fumosoroseus): Biology, ecology and use in biological control. Biocontrol Sci. Technol. 2008, 18, 865–901. [Google Scholar] [CrossRef]
- Avery, P.B.; Wekesa, V.W.; Hunter, W.B.; Hall, D.G.; McKenzie, C.L.; Osborne, L.S.; Powell, C.A.; Rogers, M.E. Effects of the fungus Isaria fumosorosea (Hypocreales: Cordycipitaceae) on reduced feeding and mortality of the Asian citrus psyllid, Diaphorina citri (Hemiptera: Psyllidae). Biocontrol Sci. Technol. 2011, 21, 1065–1078. [Google Scholar] [CrossRef]
- Mascarin, G.M.; Jaronski, S.T. The production and uses of Beauveria bassiana as a microbial insecticide. World J. Microb. Biotechnol. 2016, 32, 177. [Google Scholar] [CrossRef] [PubMed]
- Chang, G.C. Comparison of single versus multiple species of generalist predators for biological control. Environ. Entomol. 1996, 25, 207–212. [Google Scholar] [CrossRef]
- Guetsky, R.; Shtienberg, D.; Elad, Y.; Dinoor, A. Combining biocontrol agents to reduce the variability of biological control. Phytopathology 2001, 91, 621–627. [Google Scholar] [CrossRef] [PubMed]
- Otsuki, H.; Yano, S. Functionally different predators break down antipredator defenses of spider mites. Entomol. Exp. Appl. 2014, 151, 27–33. [Google Scholar] [CrossRef]
- Barbercheck, M.; Kaya, H. Competitive interactions between entomopathogenic nematodes and Beuveria bassiana (Deuteromycotina, Hyphomycetes) in soilborne larvae. Environ. Entomol. 1991, 20, 707–712. [Google Scholar] [CrossRef]
- Ansari, M.A.; Shah, F.A.; Butt, T.M. Combined use of entomopathogenic nematodes and Metarhizium anisopliae as a new approach for black vine weevil, Otiorhynchus sulcatus, control. Entomol. Exp. Appl. 2008, 129, 340–347. [Google Scholar] [CrossRef]
- Ansari, M.A.; Shah, F.A.; Butt, T.M. The entomopathogenic nematode Steinernema kraussei and Metarhizium anisopliae work synergistically in controlling overwintering larvae of the black vine weevil, Otiorhynchus sulcatus, in strawberry growbags. Biocontrol Sci. Technol. 2010, 20, 99–105. [Google Scholar] [CrossRef]
- Hussein, H.M.; Skoková Habuštová, O.; Půža, V.; Zemek, R. Laboratory evaluation of Isaria fumosorosea CCM 8367 and Steinernema feltiae Ustinov against immature states of Colorado potato beetle. PLoS ONE 2016, 11, e0152399. [Google Scholar] [CrossRef]
- Shapiro-Ilan, D.I.; Jackson, M.; Reilly, C.C.; Hotchkiss, M.W. Effects of combining an entomopathogenic fungi or bacterium with entomopathogenic nematodes on mortality of Curculio caryae (Coleoptera: Curculionidae). Biol. Control 2004, 30, 119–126. [Google Scholar] [CrossRef]
- Ansari, M.A.; Tirry, L.; Moens, M. Interaction between Metarhizium anisopliae CLO 53 and entomopathogenic nematodes for the control of Hoplia philanthus. Biol. Control 2004, 31, 172–180. [Google Scholar] [CrossRef]
- Acevedo, J.P.M.; Samuels, R.I.; Machado, I.R.; Dolinski, C. Interactions between isolates of the entomopathogenic fungus Metarhizium anisopliae and the entomopathogenic nematode Heterorhabditis bacteriophora JPM4 during infection of the sugar cane borer Diatraea saccharalis (Lepidoptera: Pyralidae). J. Invertebr. Pathol. 2007, 96, 187–192. [Google Scholar] [CrossRef] [PubMed]
- Tarasco, E.; Santiago Alvarez, C.; Triggiani, O.; Quesada Moraga, E. Laboratory studies on the competition for insect haemocoel between Beauveria bassiana and Steinernema ichnusae recovered in the same ecological niche. Biocontrol Sci. Technol. 2011, 21, 693–704. [Google Scholar] [CrossRef]
- Al Mazra’awi, M.S.; Shipp, J.L.; Broadbent, A.B.; Kevan, P.G. Dissemination of Beauveria bassiana by honey bees (Hymenoptera: Apidae) for control of tarnished plant bug (Hemiptera: Miridae) on canola. Environ. Entomol. 2006, 35, 1569–1577. [Google Scholar] [CrossRef]
- Kapongo, J.P.; Shipp, L.; Kevan, P.; Broadbent, B. Optimal concentration of Beauveria bassiana vectored by bumble bees in relation to pest and bee mortality in greenhouse tomato and sweet pepper. BioControl 2008, 53, 797–812. [Google Scholar] [CrossRef]
- Baverstock, J.; Roy, H.E.; Pell, J.K. Entomopathogenic fungi and insect behaviour: From unsuspecting hosts to targeted vectors. BioControl 2010, 55, 89–102. [Google Scholar] [CrossRef]
- Zhang, Y.X.; Sun, L.; Lin, G.Y.; Lin, J.Z.; Chen, X.; Ji, J.; Zhang, Z.; Sayto, Y. A novel use of predatory mites for dissemination of fungal pathogen for insect biocontrol: The case of Amblyseius swirskii and Neoseiulus cucumeris (Phytoseiidae) as vectors of Beauveria bassiana against Diaphorina citri (Psyllidae). Syst. Appl. Acarol. 2015, 20, 177–187. [Google Scholar] [CrossRef]
- Lin, G.Y.; Tanguay, A.; Guertin, C.; Todorova, S.; Brodeur, J. A new method for loading predatory mites with entomopathogenic fungi for biological control of their prey. Biol. Control 2017, 115, 105–111. [Google Scholar] [CrossRef]
- White, G.F. A method for obtaining infective nematode larvae from cultures. Science 1927, 66, 302–303. [Google Scholar] [CrossRef]
- Zemek, R.; Prenerová, E.; Weyda, F. The first record of entomopathogenic fungus Paecilomyces fumosoroseus (Deuteromycota: Hyphomycetes) on the hibernating pupae of Cameraria ohridella (Lepidoptera: Gracillariidae). Entomol. Res. 2007, 37, A136. [Google Scholar]
- Prenerová, E.; Zemek, R.; Weyda, F.; Volter, L. Strain of Entomopathogenic Fungus Isaria fumosorosea CCM 8367 (CCEFO.011.PFR) and the Method of Controlling Insect and Mite Pests. U.S. Patent No. 8574566, 5 November 2013. [Google Scholar]
- Prenerová, E.; Zemek, R.; Weyda, F.; Volter, L. Strain of Entomopathogenic Fungus Isaria fumosorosea CCM 8367 (CCEFO.011.PFR) and the Method for Controlling Insect and Mite Pests. EPO Patent No. EP2313488, 29 April 2015. [Google Scholar]
- Gosling, J.; Joy, B.; Steele, G.L., Jr.; Bracha, G. The Java Language Specification, 3rd ed.; Addison-Wesley Professional: Santa Clara, CA, USA, 2005; ISBN 0-321-24678-0. [Google Scholar]
- Campbell, J.F.; Gaugler, R. Inter-specific variation in entomopathogenic nematode foraging strategy: Dichotomy or variation along a continuum? Fundam. Appl. Nematol. 1997, 20, 393–398. [Google Scholar]
- Gleich, J.G.; Gilbert, F.F.; Kutscha, N.P. Nematodes in terrestrial gastropods from central Maine. J. Wildl. Dis. 1977, 13, 43–46. [Google Scholar] [CrossRef] [PubMed]
- Chase, A.; Osborne, L.; Ferguson, V. Selective isolation of the entomopathogenic fungi Beauveria bassiana and Metarhizium anisopliae from an artificial potting medium. Fla. Entomol. 1986, 69, 285–292. [Google Scholar] [CrossRef]
- Smagghe, G.; De Meyer, L.; Meeus, I.; Mommaerts, V. Safety and acquisition potential of Metarhizium anisopliae in entomovectoring with bumble bees, Bombus terrestris. J. Econ. Entomol. 2013, 106, 277–282. [Google Scholar] [CrossRef] [PubMed]
- Lin, G.; Guertin, C.; Di Paolo, S.; Todorova, S.; Brodeur, J. Phytoseiid predatory mites can disperse entomopathogenic fungi to prey patches. Sci. Rep. 2019, 9, 19435. [Google Scholar] [CrossRef] [PubMed]
- Wu, S.Y.; Wang, P.X.; Zhang, Z.K.; Xu, X.N.; Lei, Z.R. Capability of the predatory mite in carrying conidia of Beauveria bassiana and conidia vitality and virulence to Frankliniella occidentalis. Sci. Agric. Sin. 2014, 47, 3999–4006. [Google Scholar]
- Wu, S.; Gao, Y.; Smagghe, G.; Xua, X.; Lei, Z. Interactions between the entomopathogenic fungus Beauveria bassiana and the predatory mite Neoseiulus barkeri and biological control of their shared prey/host Frankliniella occidentalis. Biol. Control 2016, 98, 43–51. [Google Scholar] [CrossRef]
- Wu, S.Y.; El-Borai, F.E.; Graham, J.H.; Duncan, L.W. Saprophytic fungus Fusarium solani increases the insecticidal efficacy of the entomopathogenic nematode Steinernema diaprepesi. J. Invertebr. Pathol. 2018, 159, 87–94. [Google Scholar] [CrossRef]
- Campbell, L.R.; Gaugler, R. Mechanisms for exsheathment of entomopathogenic nematodes. Int. J. Parasit. 1991, 21, 219–224. [Google Scholar] [CrossRef]
- Womersley, C.Z. Dehydration survival and anhydrobiotic potential. In Entomopathogenic Nematodes for Biological Control; Gaugler, R., Kaya, H.K., Eds.; CRC Press: Boca Raton, FL, USA, 1990; p. 123. [Google Scholar] [CrossRef]
- Timper, P.; Kaya, H.K. Role of the second-stage cuticle of entomogenous nematodes in preventing infection by nematophagous fungi. J. Invertebr. Pathol. 1989, 54, 314–321. [Google Scholar] [CrossRef]
- Epsky, N.D.; Walter, D.E.; Capinera, J.L. Potential role of nematophagous microarthropods as biotic mortality factors on entomogenous nematodes (Rhabditida: Steinernematidae, Heterorhabditidae). J. Econ. Entomol. 1988, 81, 821–825. [Google Scholar] [CrossRef]

| Nematode | Spores | Glass Tube’s Side | ||
|---|---|---|---|---|
| Application | Centre | Galleria | ||
| Heterorhabditis bacteriophora | Conidia + nematodes × | 590,000 | 154 | 51 |
| Condia only | 608,000 | 125 | 10.8 | |
| Blastospores + nematodes × | 120,000 | 258 | 77.1 | |
| Blastospores only | 154,000 | 79 | 11.4 | |
| Steinernema feltiae | Conidia + nematodes | 527,000 | 53.1 | 1.5 |
| Condia only | 537,000 | 14.4 | 0 | |
| Blastospores + nematodes × | 126,000 | 125 | 19.8 | |
| Blastospores only | 608,000 | 125 | 10.8 | |
| Spore Dispersal Experiment | Nematode Dispersal Experiment | ||||||
|---|---|---|---|---|---|---|---|
| Categorical Predictors | df | F | p | Categorical Predictors | df | F | p |
| (1) Presence of sheath | 1 | 14.0813 | <0.001 | (1) Presence of sheath | 1 | 2.8779 | >0.05 |
| (2) Nematode species | 1 | 13.8195 | <0.001 | (2) Part of glass tube | 2 | 86.8856 | <0.001 |
| (3) Presence of nematodes | 1 | 5.0018 | <0.05 | (3) Nematode species | 1 | 1.9545 | >0.05 |
| (4) Spore type | 1 | 7.0388 | <0.01 | (4) Time | 2 | 1.1445 | >0.05 |
| 1 × 2 | 1 | 9.5566 | <0.01 | 1 × 2 | 2 | 6.0719 | <0.01 |
| 1 × 3 | 1 | 4.8463 | <0.05 | 1 × 3 | 1 | 0.4680 | >0.05 |
| 2 × 3 | 1 | 6.8541 | <0.01 | 2 × 3 | 2 | 3.6176 | <0.05 |
| 1 × 4 | 1 | 4.5062 | <0.05 | 1 × 4 | 2 | 0.0601 | >0.05 |
| 2 × 4 | 1 | 9.3411 | <0.01 | 2 × 4 | 4 | 15.9850 | <0.001 |
| 3 × 4 | 1 | 2.6101 | >0.05 | 3 × 4 | 2 | 0.2696 | >0.05 |
| 1 × 2 × 3 | 1 | 4.9220 | <0.05 | 1 × 2 × 3 | 2 | 9.6688 | <0.001 |
| 1 × 2 × 4 | 1 | 4.3586 | <0.05 | 1 × 2 × 4 | 4 | 2.4874 | >0.05 |
| 1 × 3 × 4 | 1 | 2.4981 | >0.05 | 1 × 3 × 4 | 2 | 0.0614 | >0.05 |
| 2 × 3 × 4 | 1 | 4.7677 | <0.05 | 2 × 3 × 4 | 4 | 2.8772 | <0.05 |
| 1 × 2 × 3 × 4 | 1 | 2.9877 | >0.05 | 1 × 2 × 3 × 4 | 4 | 3.7649 | <0.01 |
| error | 84 | 2.8677 | >0.05 | error | 36 | ||
Publisher’s Note: MDPI stays neutral with regard to jurisdictional claims in published maps and institutional affiliations. |
© 2020 by the authors. Licensee MDPI, Basel, Switzerland. This article is an open access article distributed under the terms and conditions of the Creative Commons Attribution (CC BY) license (http://creativecommons.org/licenses/by/4.0/).
Share and Cite
Nermuť, J.; Konopická, J.; Zemek, R.; Kopačka, M.; Bohatá, A.; Půža, V. Dissemination of Isaria fumosorosea Spores by Steinernema feltiae and Heterorhabditis bacteriophora. J. Fungi 2020, 6, 359. https://doi.org/10.3390/jof6040359
Nermuť J, Konopická J, Zemek R, Kopačka M, Bohatá A, Půža V. Dissemination of Isaria fumosorosea Spores by Steinernema feltiae and Heterorhabditis bacteriophora. Journal of Fungi. 2020; 6(4):359. https://doi.org/10.3390/jof6040359
Chicago/Turabian StyleNermuť, Jiří, Jana Konopická, Rostislav Zemek, Michal Kopačka, Andrea Bohatá, and Vladimír Půža. 2020. "Dissemination of Isaria fumosorosea Spores by Steinernema feltiae and Heterorhabditis bacteriophora" Journal of Fungi 6, no. 4: 359. https://doi.org/10.3390/jof6040359
APA StyleNermuť, J., Konopická, J., Zemek, R., Kopačka, M., Bohatá, A., & Půža, V. (2020). Dissemination of Isaria fumosorosea Spores by Steinernema feltiae and Heterorhabditis bacteriophora. Journal of Fungi, 6(4), 359. https://doi.org/10.3390/jof6040359

